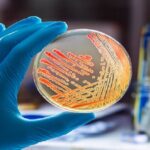

La Fondazione Irccs Ca’ Granda Ospedale Maggiore Policlinico di Milano ha indetto un concorso pubblico, per titoli ed esami, finalizzato alla copertura di 40 posti di infermiere a tempo indeterminato e pieno. Il termine per la presentazione delle domande scade il 2 gennaio 2025.
Requisiti
Per l’ammissione al concorso indetto dalla Fondazione Irccs Ca’ Granda Ospedale Maggiore Policlinico di Milano è richiesto il possesso dei seguenti requisiti genelari e specifici:
- Cittadinanza italiana, salvo le equiparazioni previste dalle leggi vigenti, ovvero di un Paese dell’Unione Europea. Possono altresì partecipare i cittadini degli Stati membri dell’Unione Europea e i loro famigliari non aventi la cittadinanza di uno Stato membro che siano titolari del diritto di soggiorno o del diritto di soggiorno permanente, i cittadini di Paesi terzi che siano titolari del permesso di soggiorno CE per soggiornanti di lungo periodo o che siano titolari dello status di rifugiato ovvero dello status di protezione sussidiaria.
- Idoneità fisica all’impiego.
- Titolo abilitante alla professione sanitaria di infermiere
- Iscrizione al relativo albo/ordine professionale. L’iscrizione al corrispondente albo/ordine professionale di uno dei Paesi dell’Unione Europea, ove prevista, consente la partecipazione ai concorsi, fermo restando l’obbligo dell’iscrizione all’albo in Italia prima dell’assunzione in servizio.
Domanda di partecipazione
La domanda di partecipazione al concorso indetto dalla Fondazione Irccs Ca’ Granda Ospedale Maggiore Policlinico di Milano dovrà essere presentata in forma telematica, connettendosi al sito https://policlinicomi.iscrizioneconcorsi.it e seguendo le istruzioni fornite dal bando.
Selezione
Le prove d’esame del concorso indetto dalla Fondazione Irccs Ca’ Granda Ospedale Maggiore Policlinico di Milano sono le seguenti:
- Prova scritta vertente su argomenti attinenti al profilo a concorso. La prova potrà consistere anche nella soluzione di quesiti a risposta sintetica o multipla.
- Prova pratica consistente nell’esecuzione di tecniche specifiche relative al profilo a concorso o nella predisposizione di atti connessi alla qualificazione professionale richiesta. La prova potrà consistere anche nella soluzione di quesiti a risposta sintetica o multipla su aspetti tecnico/pratici.
- Prova orale vertente su argomenti attinenti al profilo a concorso. Sarà inoltre accertata la conoscenza dell’uso di apparecchiature e applicazioni infomatiche più diffuse, nonché della lingua inglese.
Per ulteriori informazioni consultare il qui presente BANDO.
Redazione Nurse Times
Articoli correlati
- Aou Città della Salute e della Scienza di Torino: avviso pubblico per 4 posti da infermiere o infermiere pediatrico
- Istituto “Emilio Biazzi” di Castelvetro Piacentino: concorso per 4 posti da oss
- Ospitalità CDR Casale: concorso per l’assunzione di oss
Scopri come guadagnare pubblicando la tua tesi di laurea su NurseTimes
Il progetto NEXT si rinnova e diventa NEXT 2.0: pubblichiamo i questionari e le vostre tesi
Carica la tua tesi di laurea: tesi.nursetimes.org
Carica il tuo questionario: https://tesi.nursetimes.org/questionari

Lascia un commento